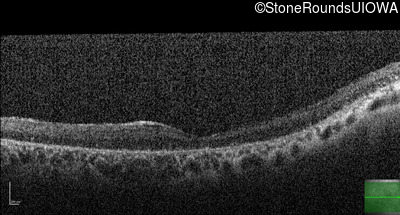
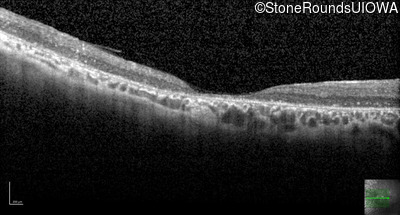
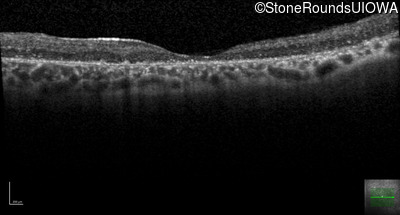
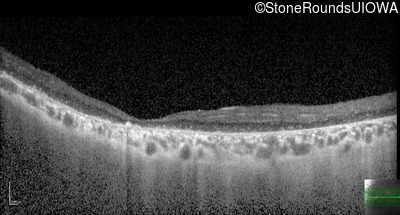
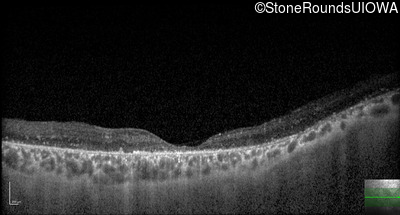
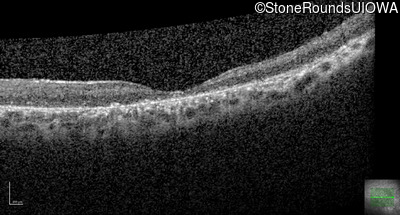
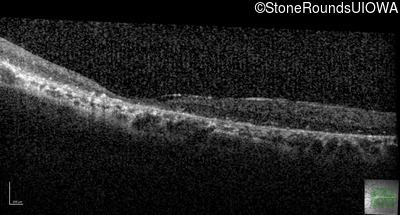
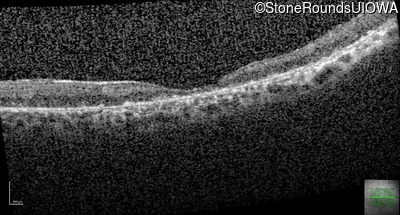
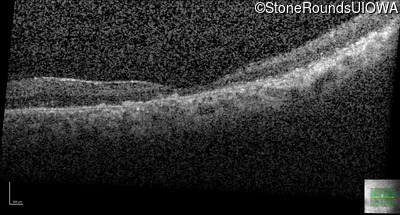
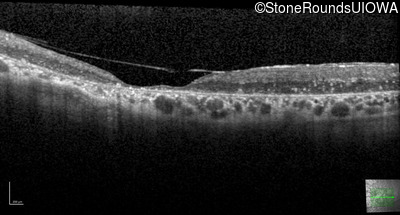
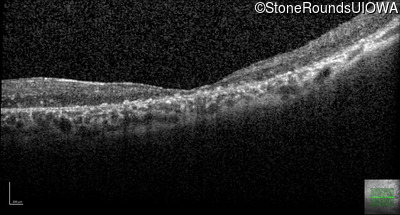
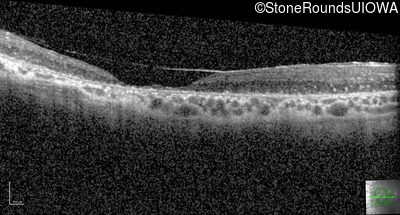
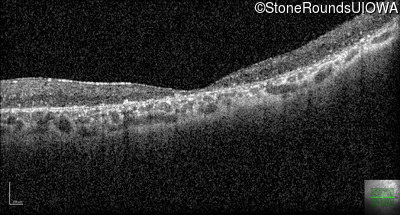
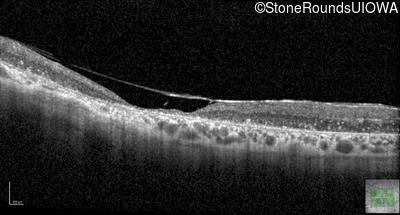
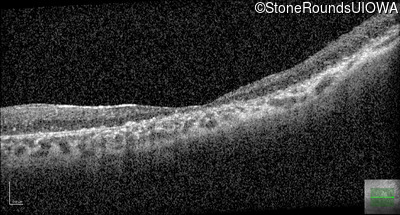
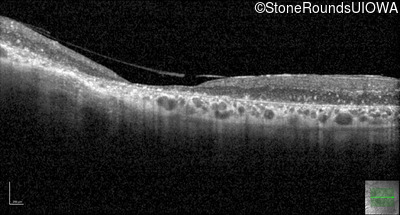
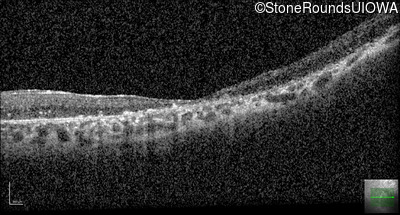
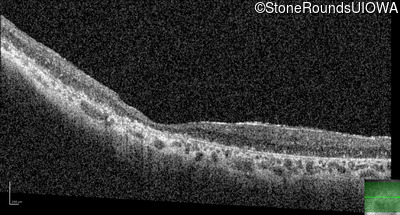
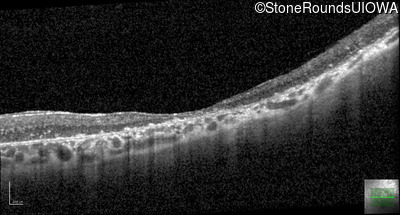
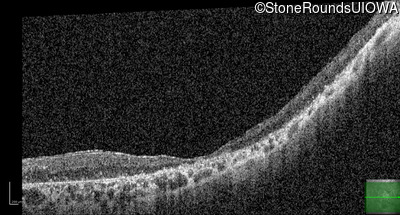

Case
SR1886
Student Mode
Wagner Disease (IIIE4)
Male
Male
Hidden
SR1886
Student Mode
Wagner Disease (IIIE4)
Male
Male
Highlighted Images
| Age at visit: 41 years | OD | OS |
|---|---|
History
This 41 year old man first came to medical attention at age 18 months when exotropia and amblyopia of his right eye were discovered. At age 11 vitreous strands and retinal vascular sheathing were seen. He has had poor night vision and constricted visual fields since his late teens. Later, at age 44 a traction retinal detachment was noted in his left eye and was treated with a scleral buckle.
| Age at visit: 9 years |
| Age at visit: 30 years |
| OD | OS | ||
|---|---|---|---|
| Age at visit: 38 years |
| Age at visit: 41 years |
| OD | OS | ||
|---|---|---|---|
| OD | OS | ||
|---|---|---|---|
| OD | OS | ||
|---|---|---|---|
| Age at visit: 42 years |
| Age at visit: 43 years |
| Age at visit: 44 years |
| OS | |||
|---|---|---|---|
| Age at visit: 44 years (Visit 2) |
| OS | |||
|---|---|---|---|
| Age at visit: 44 years (Visit 3) |
| Age at visit: 44 years (Visit 5) |
| Age at visit: 45 years |
| Age at visit: 48 years |
| Age at visit: 49 years |
| OD | OS | ||
|---|---|---|---|
| OD | OS | ||
|---|---|---|---|
| Age at visit: 50 years |
| OD | OS | ||
|---|---|---|---|
| Age at visit: 51 years |
| OD | OS | ||
|---|---|---|---|
Diagnosis & molecular findings
| Disease | Gene | Allele 1 variant(s) | Allele 2 variant(s) | Inheritance mode |
|---|---|---|---|---|
| Wagner Disease | VCAN | IVS7-1 G>A | AD |